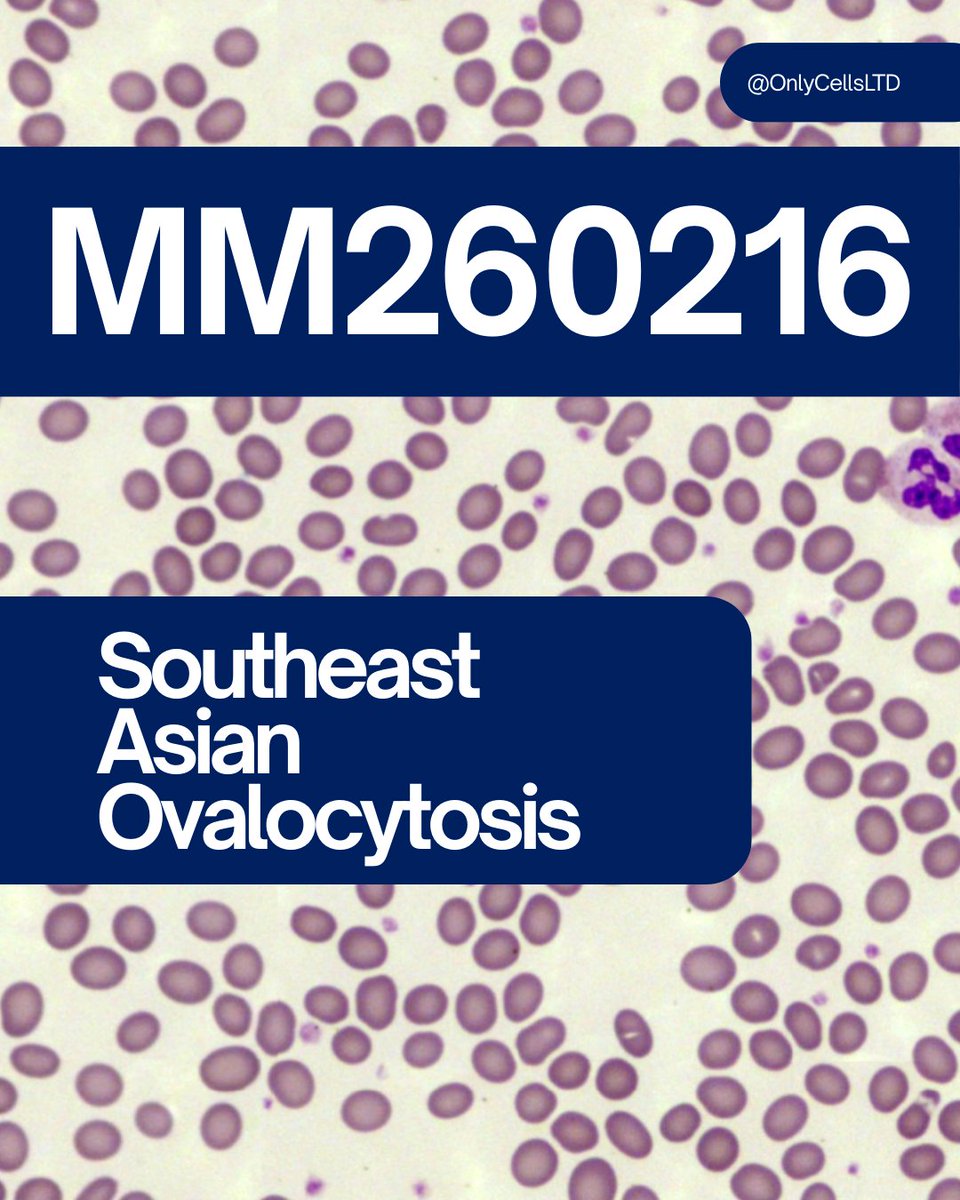
Only Cells tweet media
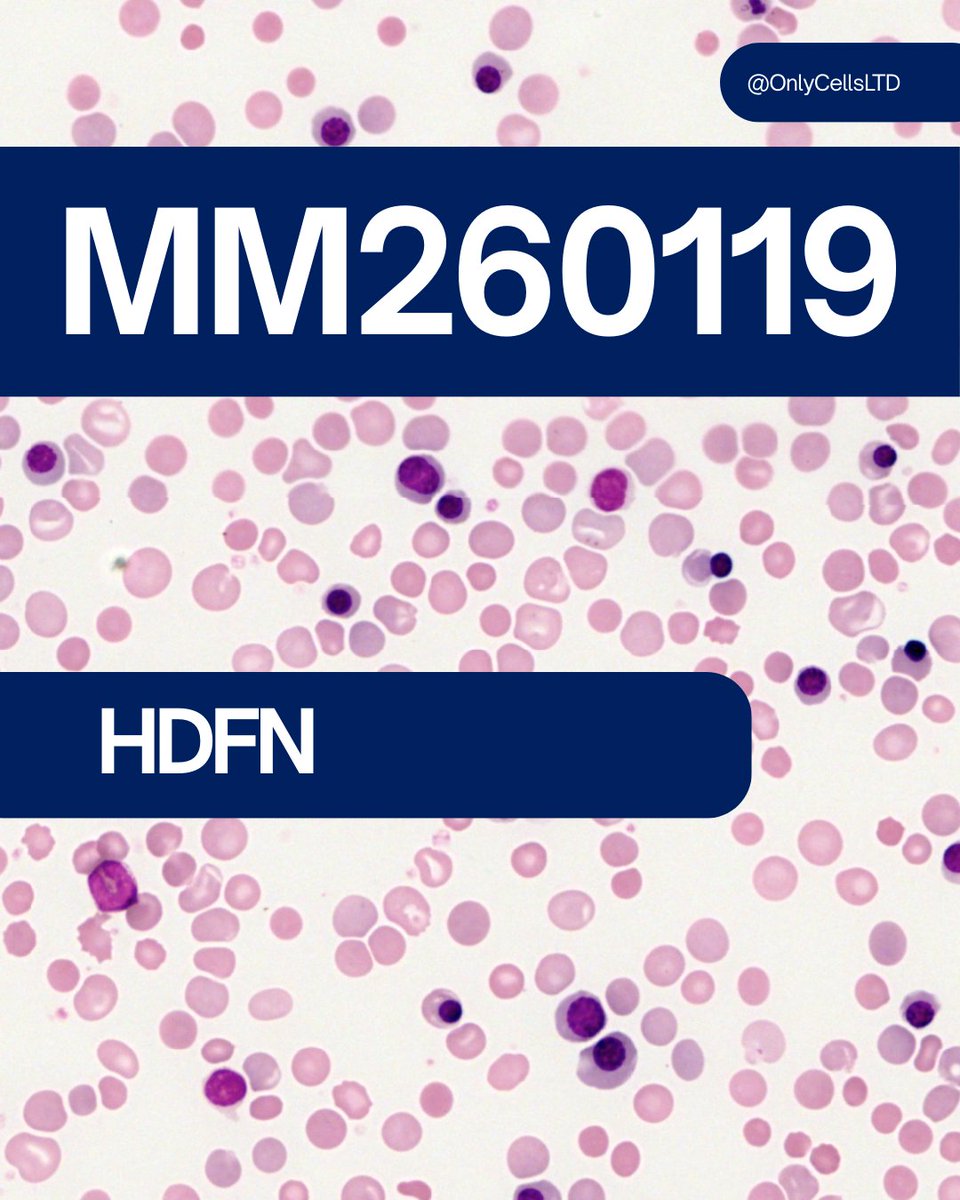
Only Cells tweet media
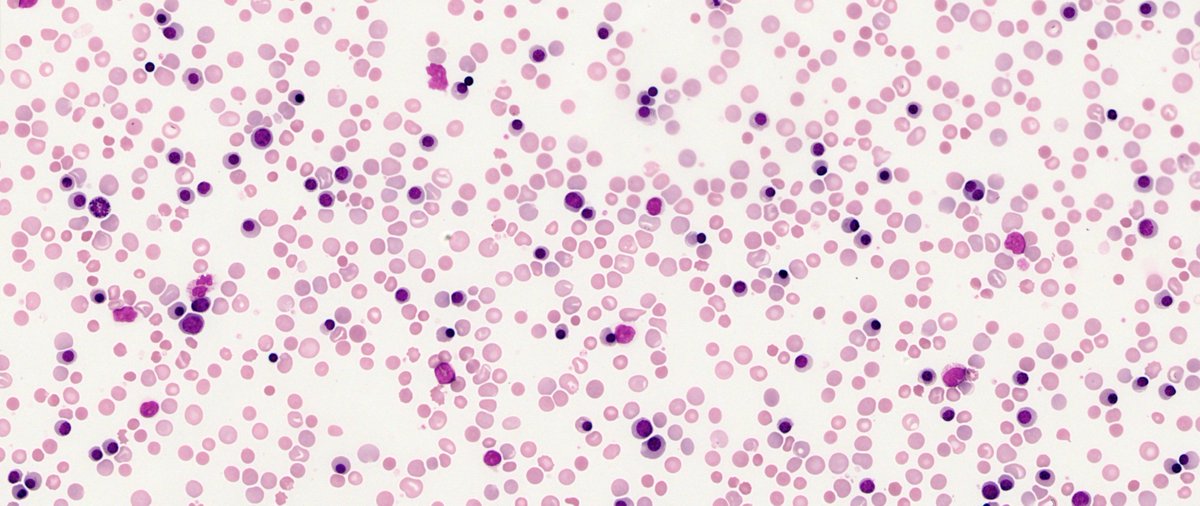
Only Cells tweet media
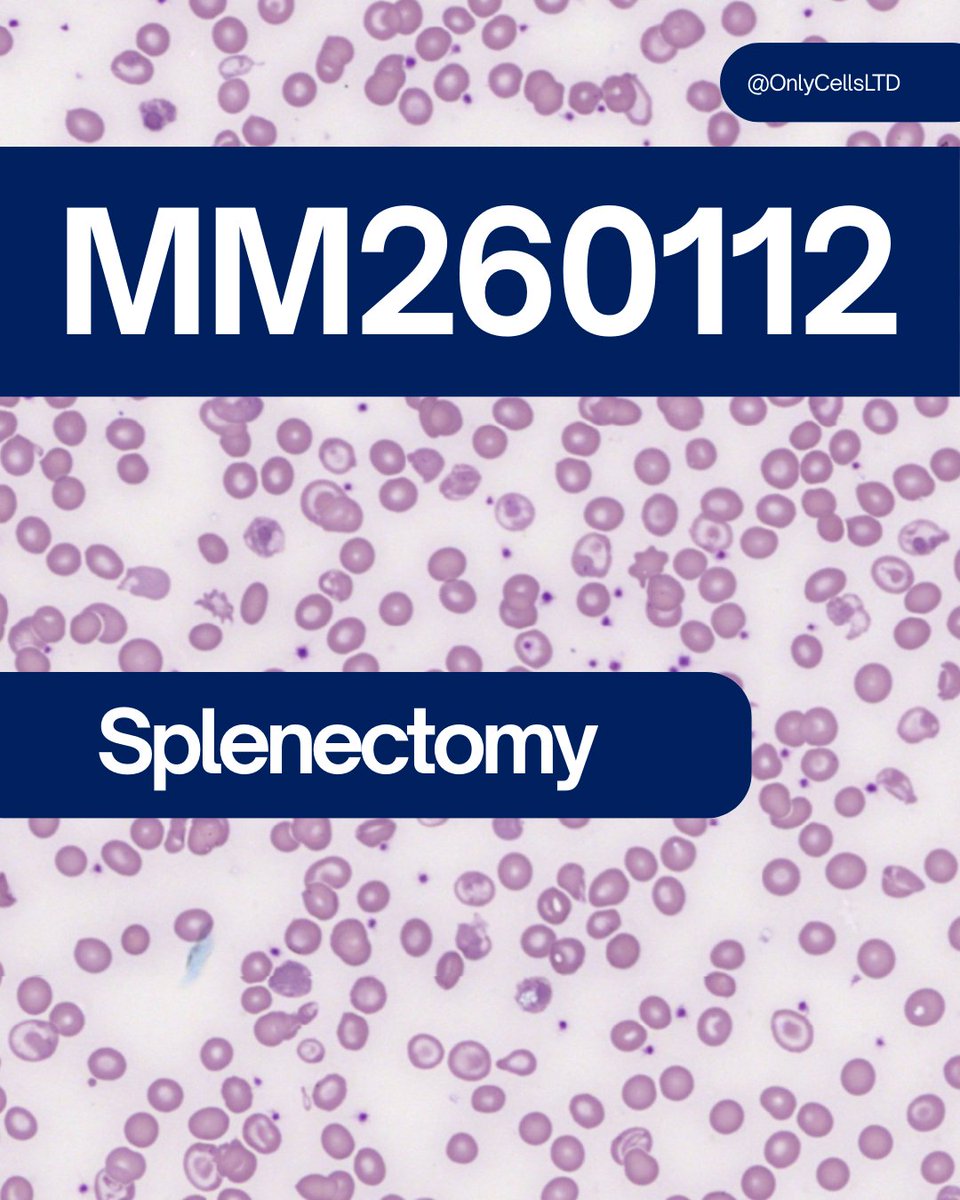
Only Cells tweet media
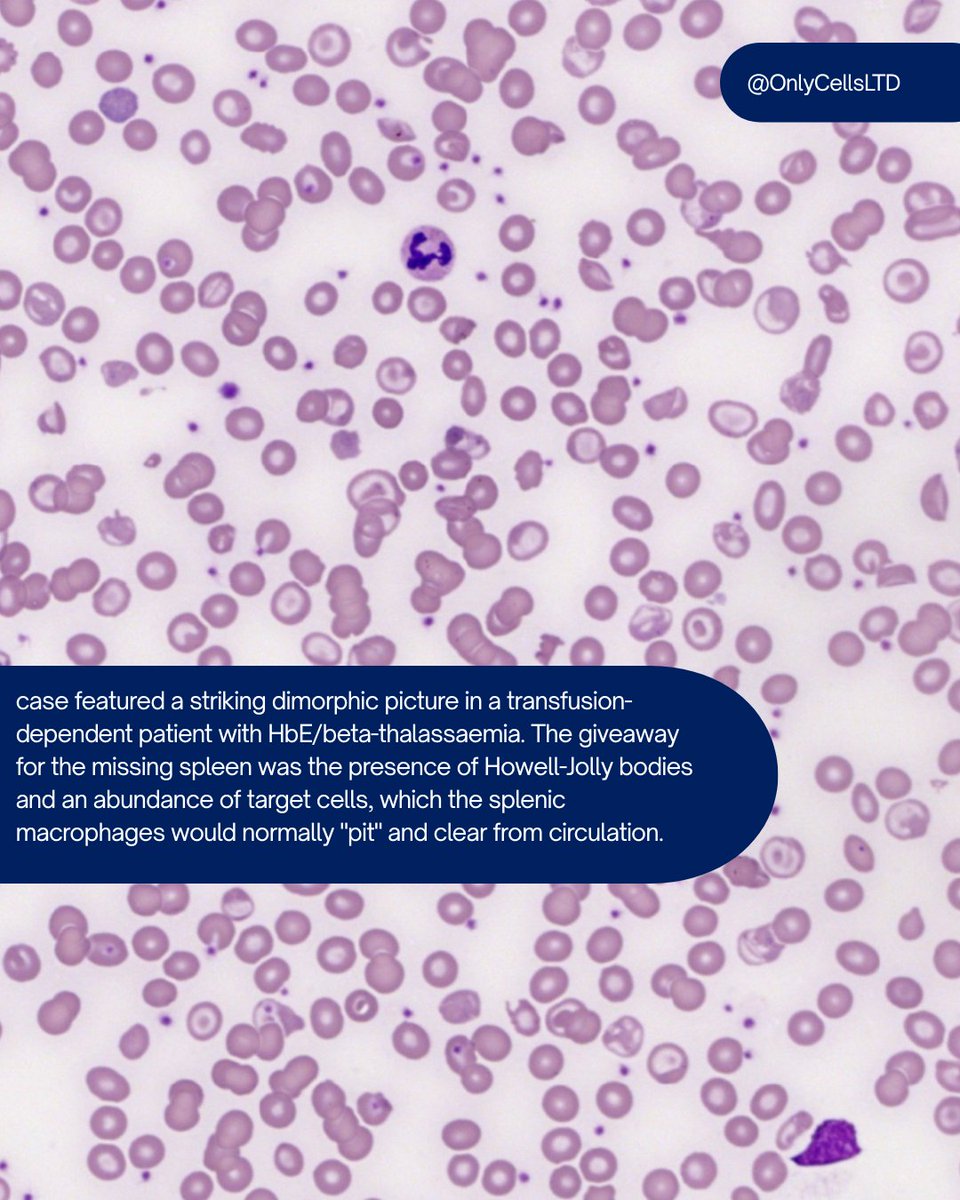
Only Cells tweet media
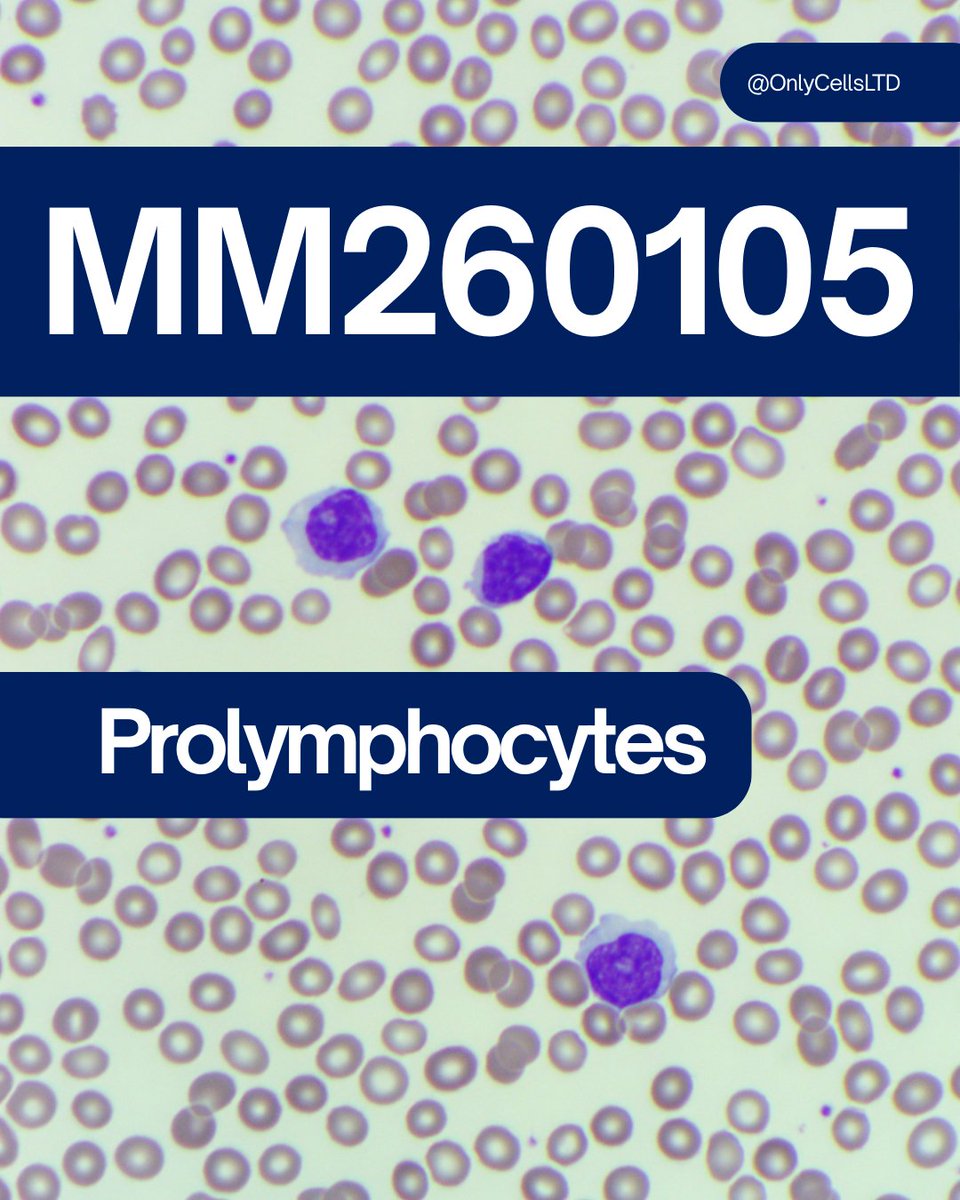
Only Cells tweet media

Only Cells
316 posts

Only Cells
@OnlyCellsLTD
Knowledge you can share. Science you can wear. Haematology 🔬 | Transfusion 🩸 | Webinars💻 | CPD📚 | Lab Life🥼 | Only Cells Shop🛒 | @BloodScientist

We’ve all been there, whether it's a long weekend day shift or at 03:00am on a night shift, the bleep is bleeping, the phone won't stop ringing and the analysers seeking attention. The urgent samples are starting to pile up and you're starting to get tired. This design wasn’t cooked up in a graphic studio; it was discovered on the bench. While scanning a blood film, I spotted this sad looking neutrophil face. It looked exactly how I felt before my first brew of the shift. Naturally, I couldn't leave it like that. The mug summarises the before and after feeling of that first warm brew of the shift (or day!). The perfect relatable gift for Biomedical Scientists, Pathologists, or anyone who knows that coffee or tea are the primary fuel of healthcare science. Question is, what is your beverage of choice? 👉 Grab yours here: onlycells.shop (Etsy, worldwide shipping available)

🩸#MorphologyMonday | Case MM260119 onlycells.co.uk/mm260119/ Today’s case comes from NICU (neonatal intensive care unit). The neonate has rapid-onset jaundice and a plummeting haemoglobin. The baby's mother is RhD Neg and missed multiple appointments during her pregnancy and so never received anti-D prophylaxis. 👉 Question: Does the film show a "suppressed" marrow or an "active, stressed" marrow response? Look closely at the presence of immature forms. What could the diagnosis be? #OnlyCells #BloodFilm #RedCells #Pregnancy #LabDiagnostics

🩸#MorphologyMonday | Case MM251110 onlycells.co.uk/mm251110/ A 28 year old female was referred to haematology after routine pre-operative blood tests revealed some abnormalities on her full blood count. She reports occasional easy bruising but no significant bleeding history, and is otherwise well. The FBC showed: - Hb: 122 g/L - WBC: 6.8 × 10⁹/L - Platelets: 62 × 10⁹/L - MCV: 89 fL - MCH: 30 pg A blood film was made and can be seen below. What do you think the diagnosis could be? #OnlyCells #BloodFilm #LabDiagnostics
